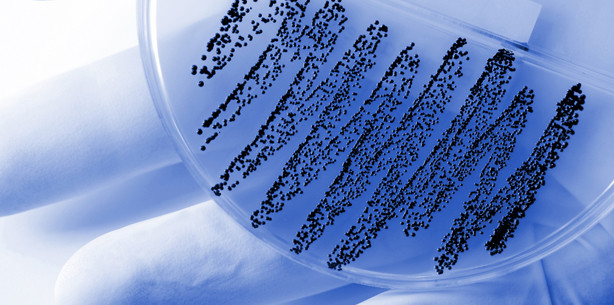
Parodontitis-Bakterien mögliche Darmkrebsauslöser

Branchenmeldungen 26.08.2013
Parodontitis-Bakterien mögliche Darmkrebsauslöser
Neueste Studien haben einen Zusammenhang von Parodontitis-Bakterien im Mund und dem Auftreten von Darmkrebs festgestellt. Wie amerikanische Wissenschaftler in zwei voneinander unabhängigen Studien1,2 herausfanden, regen sogenannte Fusobakterien (Fusobacterium nucleatum, kurz Fn) das Immunsystem an, bestimmte Zellmechanismen zu aktivieren. Dadurch werden aber auch die Schalter für bestimmte Tumorzellen aktiviert.
Fn ist ein Bakterium, welches an grampositiven Mikroorganismen im Plaque anhaftet. Es ist allein kein Pathogen, aktiviert aber durch sein Anhaften an anderen Pathogenen bestimmte Vorgänge. So produziert es toxische Metaboliten, die wiederum gesunde Zellen des umgebenden Gewebes (Fibroblasten) zerstören können.
Amerikanische Forscher haben nun Fusobakterien im Zusammenhang mit kolorektalen Karzinomen gefunden. Fn nutzt das Molekül Fusobakterium adhesin A (FadA), um an E-Cadherin zu binden. Das aktiviert β-Catenin Signale zu senden, welche die Genese von Karzinomen im Darm beschleunigen.
Die Wissenschaftler stellten fest, dass im Gewebe von gesunden Menschen wesentlich weniger FadA zu finden ist, als bei Personen, die benigne oder maligne Darmtumore haben. FadA könnte damit ein Marker für die frühe Entstehung von Darmkarzinomen darstellen.
1 Kostic et. al., Fusobacterium nucleatum Potentiates Intestinal Tumorigenesis and Modulates the Tumor-Immune Microenvironment, Cell Host & Microbe, 14.08.2013.
2 Rubinstein et. al., Fusobacterium nucleatum Promotes Colorectal Carcinogenesis by Modulating E-Cadherin/β-Catenin Signaling via its FadA Adhesin, Cell Host & Microbe, 14.08.2013.
Quelle: MNT